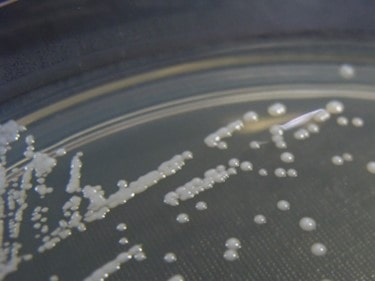
Cultivo de Candida glabrata de Nathan Reading

Candida glabrata es una levadura saprófita, clasificada dentro del género Candida y perteneciente al filo Ascomycota. Además, conforma el complejo C. glabrata incluyendo a otras dos especies: C. bracariensis y C. niveriensis (7).
Se diferencia de otras especies del género en que no es polimórfica, debido a que crece únicamente en forma de levadura (blastoconidios) y no produce pseudohifas o hifas verdaderas (12) (13); raramente se ha observado un desarrollo de pseudohifas bajo unas condiciones muy concretas de falta de nitrógeno (10). A pesar de que esta levadura, generalmente, no filamenta, sí presenta algunas características comunes del género Candida y se ha demostrado su patogenicidad como un patógeno oportunista (3) (13).
Se reproduce de forma asexual por gemación. No se ha descrito que produzca esporas sexuales o clamidosporas. Otra característica que la diferencia es que su genoma es haploide (14).
Los blastoconidios son considerablemente más pequeños en comparación con otras especies de Candida (1-4 µm) (12). En medio agar Sabouraud produce colonias lisas de consistencia blanda y de color blanco o crema y en medios cromogénicos origina colonias de color variable, de lila a púrpura (14).
Viabilidad, propagación y transmisión
Reservorio
Humano (piel, cavidad oral, tracto gastrointestinal y genitourinario), plantas y suelo (17).
Hospedadores
Humanos.
Dosis Infectiva Mínima (DIM)
Se desconoce en la actualidad.
Supervivencia ambiental
C. glabrata presenta una alta tolerancia al estrés ambiental, pudiendo sobrevivir en superficies de 102 a 150 días. Tolera temperaturas de hasta 43 ˚C-45 ˚C, siendo su temperatura óptima de crecimiento de 35 ˚C-37 ˚C; los ambientes con elevada humedad (> 70 %) favorecen su persistencia (5) (10) (14).
Formas de resistencia
No presenta formas de resistencia.
Mecanismo de propagación y transmisión
La transmisión se produce por contacto a través de la piel y las mucosas y por vía parenteral. Es frecuente la transmisión nosocomial. Se ha documentado que existe transmisión por contacto a través de las manos del personal sanitario y biomateriales y superficies inanimadas (8) (15).
C. glabrata suele formar biopelículas en sustratos inertes, especialmente en dispositivos médicos, por lo que la infección también se asocia al uso de catéteres intravenosos (1) (15).
Vías de entrada
Dérmica. Mucosas. Parenteral.
Distribución geográfica
Mundial.
Efectos sobre la salud
Grupo de riesgo
2
(Ver Anexo II RD 664/1997 )Infección
Históricamente este microorganismo era considerado un hongo saprófito no patógeno; sin embargo, la frecuencia de infecciones producidas por este agente ha aumentado significativamente en los últimos años. Actualmente es una de las causas más frecuentes de candidiasis después de C. albicans; su prevalencia varía según el área geográfica (3) (13).
A diferencia de otras especies de Candida, la incidencia de C. glabrata es mayor en adultos que en niños, y menor en recién nacidos (12).
Produce candidiasis o moniliasis, una infección superficial que afecta a la piel (intertrigo), a las uñas (paroniquia o perionixis) y a las mucosas (oral, genitourinaria o digestiva). En la cavidad oral se considera un patógeno oportunista y fundamentalmente se aísla en candidiasis vulvovaginal. Los síntomas son leves, como enrojecimiento, picazón y malestar (13) (15).
En general, afecta en mayor medida a pacientes inmunocomprometidos, debilitados o ingresados en las UCI, en los que puede producir micosis sistémica grave y candidemia, con altas tasas de mortalidad (12). Se asocia a un uso previo de medicamentos antibacterianos y antifúngicos, al uso de catéteres intravenosos o una hospitalización prolongada (8).
Se ha documentado que puede producir infecciones mixtas, en asociación con otras especies de Candida (13) (15).
Efectos alérgicos (Ver Anexo II RD 664/1997 ) / (Ver Allergen )
No se han descrito.
Efectos tóxicos (Ver Anexo II RD 664/1997 )
No se han descrito.
Efectos cancerígenos (Ver International Agency for Research On Cancer - IARC )
No se han descrito.
Efectos en la maternidad
Hasta el momento no se ha hallado relación entre la infección y la evolución del embarazo. No hay datos concretos de C. glabrata, pero se ha documentado que la levadura del género Candida puede considerarse un patógeno para el neonato, dando lugar a candidiasis perinatal.
Puede producir candidiasis cutánea congénita, que es una infección intrauterina que se adquiere por vía ascendente desde el tracto genital de la madre y se manifiesta de forma sistémica o cutánea en los seis primeros días de vida.
Por otro lado, puede causar candidiasis cutánea neonatal, que es una infección adquirida durante el parto al pasar por el canal del parto o posnatalmente. Se caracteriza por la candidiasis oral y la dermatitis del pañal.
A pesar de la alta prevalencia de candidiasis vaginal durante el embarazo, las candidiasis perinatales son cuadros poco frecuentes. Concretamente, la incidencia de C. glabrata en recién nacidos es baja (4) (10) (11).
Enfermedad
| CIE-10 | Nombre | Enfermedad de Declaración Obligatoria |
|---|---|---|
| B37 | Candidiasis | No |
Actividades laborales con riesgo
Clasificación Nacional de Actividades Económicas (CNAE)
| CNAE 2009 | Descripción |
|---|---|
| A0112 | Cultivo de arroz |
| E3700 | Recogida y tratamiento de aguas residuales |
| E3811 | Recogida de residuos no peligrosos |
| E3900 | Actividades de descontaminación y otros servicios de gestión de residuos |
| N7210 | Investigación y desarrollo experimental en ciencias naturales y técnicas |
| O8123 | Otras actividades de limpieza |
| O8130 | Actividades de jardinería |
| R8610 | Actividades hospitalarias |
| R8621 | Actividades de medicina general y de medicina familiar y comunitaria |
| R8623 | Actividades odontológicas |
| R8699 | Otras actividades sanitarias n.c.o.p. |
| R8710 | Asistencia en establecimientos residenciales con cuidados sanitarios |
| T9621 | Peluquerías y barberías |
Clasificación Nacional de Ocupaciones (CNO)
| CNO 2011 | Descripción |
|---|---|
| 2111 | Médicos de familia |
| 2112 | Otros médicos especialistas |
| 2121 | Enfermeros no especializados |
| 2122 | Enfermeros especializados (excepto matronos) |
| 2151 | Odontólogos y estomatólogos |
| 2157 | Podólogos |
| 3313 | Técnicos en anatomía patológica y citología |
| 3314 | Técnicos en laboratorio de diagnóstico clínico |
| 3316 | Técnicos en prótesis dentales |
| 3321 | Técnicos superiores en higiene bucodental |
| 5611 | Auxiliares de enfermería hospitalaria |
| 5612 | Auxiliares de enfermería de atención primaria |
| 5622 | Técnicos de emergencias sanitarias |
| 5629 | Trabajadores de los cuidados a las personas en servicios de salud no clasificados bajo otros epígrafes |
| 5710 | Trabajadores de los cuidados personales a domicilio |
| 5812 | Especialistas en tratamientos de estética, bienestar y afines |
| 6120 | Trabajadores cualificados en huertas, invernaderos, viveros y jardines |
| 9229 | Otro personal de limpieza |
| 9441 | Recogedores de residuos |
| 9442 | Clasificadores de desechos, operarios de punto limpio y recogedores de chatarra |
| 9443 | Barrenderos y afines |
| 9512 | Peones agrícolas en huertas, invernaderos, viveros y jardines |
Prevención y control
Desinfectantes
Hipoclorito sódico > 0,39 % durante un minuto; hipoclorito sódico al 0,825 % (dilución 1:10) durante un minuto; ácido peracético 1200 ppm, peróxido de hidrógeno < 1 % y ácido acético durante tres minutos; peróxido de hidrógeno al 1,4 % durante tres minutos y al 0,5 % durante diez minutos (2).
Inactivación física
No hay información específica para C. glabrata, pero la mayoría de las especies del género Candida se inactivan con vapor saturado a 121 °C durante al menos 15 minutos. La radiación ultravioleta puede contribuir a la eliminación de biopelículas de Candida (6).
Antimicrobianos
Las infecciones por C. glabrata son difíciles de tratar por sus características genéticas. Presentar un genoma haploide hace que se facilite la adquisición de resistencia secundaria a ciertos medicamentos antimicóticos, como son los comúnmente utilizados azoles, principalmente el fluconazol (8) (12) (13).
Por otro lado, sí es susceptible, generalmente, a los derivados poliénicos, como la nistatina y la anfotericina B, y tiene una alta sensibilidad a la 5-fluorocitosina (14). También es utilizado el tratamiento antifúngico con equinocandinas contra C. glabrata; sin embargo, se ha observado una disminución de la susceptibilidad a este tratamiento, ya que se han detectado algunas cepas resistentes (9) (11).
Vacunación
No disponible.
Medidas preventivas generales
Evitar el exceso de humedad y de temperatura en los locales de trabajo.
Orden y limpieza en el lugar de trabajo, limpieza y desinfección de instalaciones, equipos y herramientas.
Guardar la comida en lugares y condiciones adecuadas (refrigeración), no comer en el lugar de trabajo, ni con la ropa o manos sucias.
Higiene personal, mantener la piel limpia y seca, especialmente en las zonas de los pliegues, lavado de manos después de tocar materiales o elementos potencialmente contaminados. Utilizar ropa de trabajo que permita la transpiración y evite la sudoración excesiva. Cambiarse la ropa o el calzado mojado o húmedo.
No compartir objetos personales.
Precauciones en centros sanitarios
En hospitales o centros sanitarios, adoptar las Precauciones Estándar (19).
EPI
Protección de las manos: guantes de protección frente a microorganismos para manipular sustancias, pacientes o equipos que pueden estar contaminados (véase la NTP 1143) (18).
Protección ocular: gafas de protección de montura universal en caso de riesgo de contacto accidental mano/guante contaminado-ojo, o pantalla de protección facial en caso de riesgo de exposición por salpicaduras (símbolo de marcado en montura: 3).
Seguridad en laboratorio
Nivel de contención: 2
Los principales riesgos son la exposición de las mucosas a gotas o aerosoles, el contacto con fluidos y tejidos infecciosos, la inoculación y la ingesta accidental.
Las muestras más peligrosas son especímenes biológicos como el esputo, lavados bronquiales, heces, orina, tejidos (piel o mucosa), exudados de heridas, líquido cefalorraquídeo y sangre.
Se requieren las prácticas y la contención de un nivel 2 de bioseguridad. Limitar el número de trabajadores que tienen acceso al laboratorio y velar por el cumplimiento de las medidas higiénicas. Aplicación de procedimientos adecuados de limpieza y desinfección. Limitar el empleo de material cortante o punzante. Utilizar cabina de seguridad biológica en aquellas operaciones que impliquen la generación de aerosoles, proyecciones o salpicaduras. Uso de ropa de trabajo. Utilizar guantes de protección frente a microorganismos en el caso de contacto con muestras contaminadas.
Bibliografía
- Brunke, S., & Hube, B. (2013). Two unlike cousins: Candida albicans and C. glabrata infection strategies. Cellular microbiology, 15(5), 701-708. DOI: 10.1111/cmi.12091.
- Cadnum, J., Shaikh, A., Piedrahita, C., Sankar, T., et al. (2007). Effectiveness of disinfectants against Candida auris and other Candida species. Infection control and hospital epidemiology, 38(10), 1240-1243. DOI: 10.1017/ice.2017.162.
- Castrejón, N. S., Castillo, J., Baltierra, S. L., Hernández, J. C., & García, B. E. (2022). Candida glabrata is a succesful pathogen: An artist manipulating the immune response. Microbiological research, 260. DOI: 10.1016/j.micres.2022.127038.
- Jasso, L. (2011). Infecciones congénitas de baja frecuencia en los neonatos. Algunos aspectos relevantes. Boletín Médico del Hospital Infantil de México, 68(1), 7-20.
- Kramer, A., Schwebke, I., & Kampf, G. (2006) How long do nosocomial pathogens persist on inanimate surfaces? A systematic review. BMC Infectious diseases, 6(130). DOI: 10.1186/1471-2334-6-130.
- Li, J., Hirota, K., Yumoto, H., Matsuo, T., Miyake, Y., & Ichikawa, T. (2010). Enhanced germicidal effects of pulsed UV-LED irradiation on biofilms. Journal of applied microbiology, 109(6): 2183-2190. DOI: 10.1111/j.1365-2672.2010.04850.x.
- Pemán, J., & Quindós, G. (2016). Aspectos actuales de las enfermedades invasoras causadas por Candida y otros hongos levaduriformes. Revista iberoamericana de micología, 33(3), 133-139. DOI: 10.1016/j.riam.2015.10.001.
- Pfaller, M. A. (1996). Nosocomial candidiasis: emerging species, reservoirs, and modes of transmission. Clinical infectious diseases, 22(2), 89-94. DOI: 10.1093/clinids/22.supplement_2.s89.
- Rodrigues, C. F., Silva, S., & Henriques, M. (2014). Candida glabrata: a review of its features and resistance. duropean Journal of clinical microbiology & infectious diseases, 33: 673-688. DOI: 10.1007/s10096-013-2009-3.
- Roetzer, A., Gabaldón, T., & Schüller, C. (2011) From Saccharomyces cerevisiae to Candida glabrata in a few easy steps: important adaptations for an opportunistic pathogen. FEMS Microbiology letters, 314(1), 1-9. DOI: 10.1111/j.1574-6968.2010.02102.x.
- Sánchez, J. M., Vicente, A., & González, M. A. (2005). Manifestaciones cutáneas en las candidiasis perinatales. Piel, 20(9), 450-456. DOI: 10.1016/S0213-9251(05)72324-8.
- Silva, S., Negri, M., Henriques, M., Oliveira, R., Williams, D. W., & Azeredo, J. (2012). Candida glabrata, Candida parapsilosis and Candida tropicalis: biology, epidemiology, pathogenicity and antifungal resistance. FEMS Microbiology reviews, 36(2), 288-305. DOI: 10.1111/j.1574-6976.2011.00278.x.
- Tapia, C. (2008). Candida glabrata. Revista chilena de infectología, 25(4), 293. DOI: 10.4067/S0716-10182008000400009.
- Torres-Rodríguez, J. M., Morera, Y., & López, O. Candida glabrata: un patógeno emergente. Sociedad Española de Enfermedades Infecciosas y Microbiología Clínica (SEIMC).
- Vazquez, J. A., Dembry, L. M., Sanchez, V., Vazquez, M. A., Sobel, J. D., Dmuchowski, C., & Zervos, M. J. (1998). Nosocomial Candida glabrata colonization: an epidemiologic study. Journal of clinical microbiology, 36(2). DOI: 10.1128/JCM.36.2.421-426.1998.
- Comisión de Salud Pública del Consejo Interterritorial del Sistema Nacional de Salud. Ministerio de Sanidad y Consumo. (2001). Protocolo de vigilancia sanitaria específica para los/as trabajadores/as expuestos a agentes biológicos.
- Institut National de Recherche et de Sécurité (INRS). (2023). Candida glabrata. BAse d'OBservation des Agents Biologiques (BAOBAB).
- Instituto Nacional de Seguridad y Salud en el Trabajo (INSST). (2020). Nota Técnica de Prevención (NTP) 1143: Guantes de protección contra microorganismos.
- Servicio Riojano de Salud. (2008). Precauciones de aislamiento en centros sanitarios.